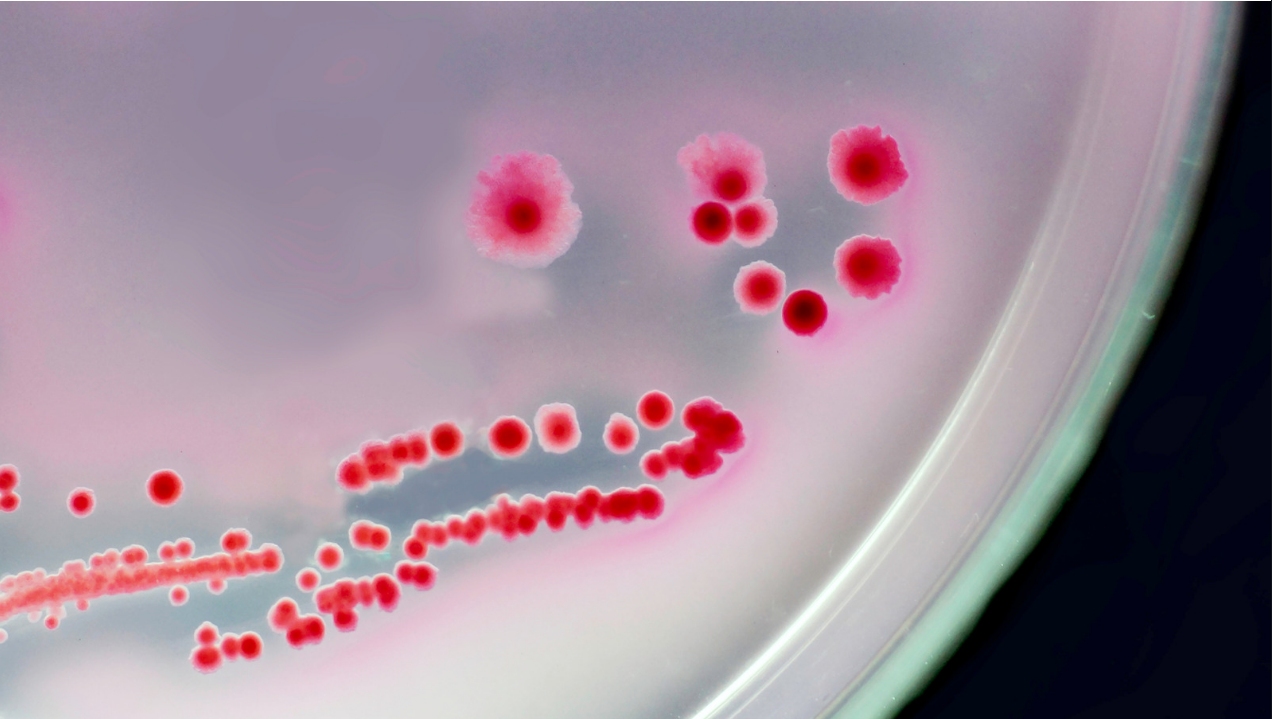

Oral Ingestion Of Latex
Big Tit Massage
Scort Tijuana
Sf Bbw Escort
Cute Naked Little Korean Girl
Sound mistress
Karyn Parsons Nude Ass
Nude Bipasha Basu
Black T Girls
Russian Pov Tube
Emma's Femdom
Reverse Cowgirl Sluts
Ssbbw Caramel
Shoking handjob image
Oral Ingestion Of Latex 144 photos